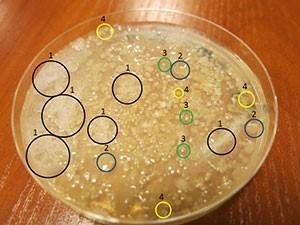

Po żniwach czas na BIOGEN-REWITAL PRO+

Jeszcze jeden cykl wegetacyjny się nie skończył, a już trzeba myśleć o następnym. Zanim jednak posiejemy nowe uprawy, czeka nas okres podejmowania ważnych decyzji. Co zrobić z resztkami pożniwnymi, słomą? Sprzedać czy też zagospodarować na polu? Gospodarstwa mające produkcję zwierzęcą nie mają takiego dylematu.
Odpowiedź jest banalnie prosta – przerobić na najlepszy nawóz jakim jest obornik. Obecnie jednak dostęp do naturalnych nawozów organicznych jest bardzo ograniczony. Ekonomika produkcji zwierzęcej wymusiła na producentach centralizowanie tej produkcji i powiększanie stad. Takie gospodarowanie spowodowało, że są miejsca o nadmiernej produkcji nawozów organicznych (częstokroć będąc problemem i zagrożeniem ekologicznym) z jednej strony, a z drugiej, zmusiło to gospodarstwa roślinne do szukania rozwiązań na zbilansowanie masy organicznej w glebie.
Doświadczenia minionych lat, czasu zachłystnięcia się nawożeniem mineralnym, pokazują, że do uzyskania stabilnych plonów nie wystarczy tylko nawożenie mineralne. Musimy jeszcze pamiętać o utrzymaniu poziomu masy organicznej w glebie, która jest podstawowym substratem do przemian w stosunkowo trwałą jej formę, próchnicę. W ofercie handlowej PROCAM od kilku lat głównym produktem stanowiącym składową rewitalizacji środowiska glebowego jest najlepszy na rynku biopreparat BIOGEN-REWITAL PRO+ zbudowany z kompozytu mikrobiologicznego (bakterie celuloityczne, nitryfikacyjne, sanitarne, lipolityczne) zestawionego z niepatogennych mikroorganizmów oraz specjalnej pożywki startowej.
Bakterie, stanowiące podstawowy składnik BIOGEN-REWITAL PRO+, wprowadzone w środowisko glebowe, potrafią tworzyć wzajemnie uzupełniające się, korzystne dla przebiegu rewitalizacji, układy symbiotyczne. Nie produkują substancji, mogących mieć ujemny wpływ na wyniki produkcyjne w uprawie roślin oraz jakość produktów i surowców pochodzenia roślinnego, a także zwierzęcego, w przypadku wykorzystywania produktów roślinnych z potraktowanych biopreparatem plantacji jako pasz dla zwierząt. Wprowadzone do środowiska, przywracają korzystną równowagę mikrobiologiczną w ekosystemie. Mogą rozwijać i rozmnażać się w zmiennych warunkach, jakie występują w glebie, w trakcie realizacji procesu rewitalizacji (warunki tlenowe, beztlenowe, wahania pH, temperatury itp.). W wyniku różnorodnych procesów biochemicznych są zdolne powodować redukcję mikroflory patogennej, w zanieczyszczonym mikrobiologicznie środowisku glebowym. Przy aplikacji preparatu należy pamiętać aby gleba była wilgotna i jak najszybciej należy zaaplikowany preparat przykryć niewielką ilością gleby np. przy siewie. Idealnie byłoby wykonać to „zaszczepienie” podczas lekkiego opadu deszczu. Teraz jest najlepszy czas aby przed siewami rzepaku, a zwłaszcza zbóż zasiedlić bakteriami glebę aby wykonały swoją pożyteczną i zaplanowaną przez nas pracę!
REWITAL PRO+ wprowadzony do gleby inicjuje w niej szereg korzystnych zmian, w wyniku których następuje:
• Przywracanie równowagi mikrobiologicznej ekosystemu poprzez korzystną regenerację zdegradowanej różnymi czynnikami mikroflory glebowej (jej rewitalizację po degradującym wpływie erozji, środków chemicznych, ognia i innych tego typu czynnikach).
• Uruchamianie w środowisku glebowym pożądanych reakcji biochemicznych mających istotny wpływ na gospodarkę azotu, fosforu oraz związków siarki w glebie, a pośrednio także w uprawianych na traktowanych biopreparatem glebach – uprawach roślinnych.
• Uruchamianie wykorzystywania przez rośliny składników pokarmowych zawartych w glebie w formach dotychczas niedostępnych dla roślin.
• Przyspieszona mineralizacja resztek pożniwnych roślin, obornika i innych substancji naturalnych wykorzystywanych rolniczo w uprawach roślinnych jako nawozy organiczne.
• Ograniczenie przykrych zapachów podczas rolniczego wykorzystywania na polach uprawnych obornika oraz gnojówek i gnojowic.
• Redukcja w środowisku glebowym chorobotwórczych dla roślin bakterii, wirusów i grzybów oraz zmniejszenie emisji do środowiska chorobotwórczych dla ludzi i zwierząt zanieczyszczeń mikrobiologicznych w pobliżu traktowanych biopreparatem pól uprawnych.
• Ograniczenie chorób roślin poprzez szybki rozkład materii organicznej a na niej zawartych owocników i zarodników chorób grzybowych roślin uprawnych, warzywniczych i sadowniczych.
• Wzrost żyzności gleby oraz poprawa wartości biologicznej produktów roślinnych.
• Bardzo istotny wzrost plonowania roślin oraz opłacalności produkcji.
Ochrona roślin przed szkodliwymi patogenami glebowymi:
• symbioza z korzeniami roślin np.: bakterie z rodzaju Pseudomonas i Bacillus, wchodząc w układ sybiotyczny z korzeniem rośliny, wytwarzają substancje specyficzne (antybiotyki, bakteriocyny),
• wyparcie z gleby patogenów grzybowych i bakteryjnych, ogranicza verticiliozy, fuzariozy inne odglebowe,
• zahamowany rozwój pleśni przyczynia się do zredukowania ryzyka obniżenia odporności roślin,
• metabolity wytwarzane przez pożyteczne mikroorganizmy przyczyniają się do przyspieszenia rozwoju i lepszego wzrostu rośliny.
Pomiary długości korzeni i liści kukurydzy 21 dni po aplikacji
Badania
Zapraszamy do zapoznaniem się z wynikami badania wpływu trzyletniego stosowania naszego preparatu na mikroflorę glebową.
Kontrola:

Grzyby pleśniowe (3 - kolor czerwony) są antagonistami pożytecznych bakterii glebowych - zmniejszają ich populację. Mitotoksyny odpowiedzialne są za obniżenie odporności roślin, powodują mniejszy wzrost roślin, konkurując o wodę i składniki odżywcze, obniżają jakość przetwórcza i konsumpcyjną produkowanej rośliny. Promieniowce (1) odpowiadają za rozkład ligniny, z której powstają kwasy humusowe (składnik próchnicy gleby), oraz antybiotyki przeciwko bakteriom i grzybom patogennym. Populacja promieniowców w próbie kontrolnej była bardzo niska.
Pierwszy rok stosowania:
Po pierwszym roku stosowania REWITAL PRO+ zaobserwowano:
• redukcję grzybów pleśniowych w glebie;
• znaczący wzrost populacji promieniowców;
• zwiększenie ilości bakterii z rodzaju Pseudomonas, Bacillus oraz Cellulomonas.
Drugi rok stosowania:
W porównaniu do efektu po jednorocznej aplikacji wzrosły:
• populacja promieniowców;
• populacja bakterii z rodzaju Pseudomonas i Cellulomonas.
Trzeci rok stosowania:
Po trzecim roku stosowania promieniowce dominowały na posiewach, nie odnotowano ponadto obecności pleśni w glebie.
Źródło: materiały firmowe PROCAM





0 komentarzy
Rekomendowane komentarze
Brak komentarzy do wyświetlenia